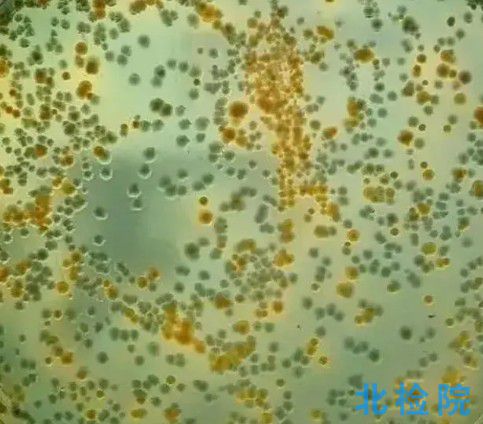

電子級高純水,海洋生物生態試驗,礦泉水,污廢水及再生水。測試項目:測試項目:可見物,溶解性總固體,pH,偏硅酸,氟化物,氯化物,硫酸鹽,耗氫量,總硬度,鍶,鋰,鈉,鈣,總堿度,磷酸鹽,產氣英膜梭菌,硫化物,翻酸鹽,226鐳放射性,鉀,鈣,鎂等。
測試標準
GB/T 1576-2018工業鍋爐水質
GB 3097-1997海水水質標準
GB 3838-2002地表水環境質量標準
GB/T 3839-1983制訂地方水污染物排放標準的技術原則與方法
GB 5084-2021農田灌溉水質標準
GB 5749-2006生活飲用水衛生標準
GB 5749-2022生活飲用水衛生標準
GB/T 5750.1-2006生活飲用水標準檢驗方法總則
GB/T 5750.3-2006生活飲用水標準檢驗方法 水質分析質量控制
GB/T 6903-2022鍋爐用水和冷卻水分析方法 通則
GB/T 6920-1986水質 PH值的測定 玻璃電極法
GB/T 7466-1987水質 總鉻的測定
GB/T 7467-1987水質 六價鉻的測定 二苯碳酰二肼分光光度法
GB/T 7469-1987水質 總汞的測定 高錳酸鉀-過硫酸鉀消解法 雙硫腙分光光度法
GB/T 7470-1987水質 鉛的測定 雙硫腙分光光度法
GB/T 7471-1987水質 鎘的測定 雙硫腙分光光度法
GB/T 7472-1987水質 鋅的測定 雙硫腙分光光度法
GB/T 7475-1987水質 銅、鋅、鉛、鎘的測定 原子吸收分光光度法
GB/T 7476-1987水質 鈣的測定 EDTA滴定法
GB/T 7477-1987水質 鈣和鎂總量的測定 EDTA滴定法
參考樣品: 海洋生物 | 酞酸酯 | 電子工業用水合銻酸鈉 | 油藏注水 | 礦泉水 | 水生生物 | 水質生物 | 污廢水及再生水 | 葡聚糖 | 海水溶解氧測量儀 |
-
苯氧乙酸檢測
檢測項目:苯氧乙酸(殘留,雜質),檢測標準:DB64/T 1493-2017豆芽中赤霉素、6-芐基腺嘌呤、4-氯苯氧乙酸、2,4-滴的測定 液相色譜-串聯質譜法
2022-11-11 瀏覽量:2
-

-

-

-

-
弧菌檢測
檢測項目:弧菌數量,檢測標準:DIN EN ISO 11348-2-2009水的質量 關于費氏弧菌發光水樣的抑制作用的測定(發光細菌試驗) 第2部分:采用干細菌法
2022-11-11 瀏覽量:1
-

-
渾濁度檢測
檢測項目:渾濁度檢測,檢測標準:NY/T 1156.17-2009農藥室內生物測定試驗準則 殺菌劑 第17部分:抑制玉米絲黑穗病菌活性試驗 渾濁度-酶聯板法。
2022-11-11 瀏覽量:1
-
服務保障 一對一品質服務
-
定制方案 提供非標定制試驗方案
-
保密協議 簽訂保密協議,嚴格保護客戶隱私
-
全國取樣/寄樣 全國上門取樣/寄樣/現場試驗





